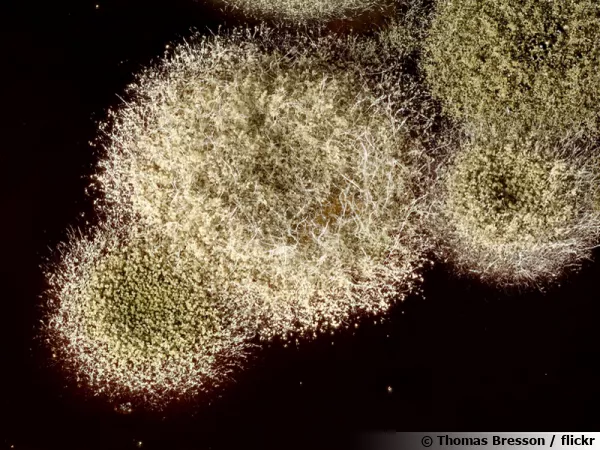

Moisissures, levures et autres micro-champignons
Entre l'animal et le végétal, le champignon occupe une place prépondérante dans la biologie même sous sa forme microscopique. Les levures et les moisissures font partie du règne fongique et en sont les dignes représentantes malgré leur discrétion.
Les champignons microscopiques
Nommés 'Micro-mycètes' ces champignons ne sont pas toujours visibles à l’œil nu. La levure servant dans les préparations culinaires ou pour réaliser des boissons, mais aussi les moisissures qui ornent les fromages font partie des micro-mycètes.
Les levures
Ces micro-organismes ne sont composés que d'une seule cellule qui mise au contact de l'oxygène, de la chaleur, ou d'élément nutritifs va se reproduire en se divisant. De bonnes conditions doivent donc être réunies. Si elles ne le sont pas, les levures sont capables de devenir inactives et d'entrer dans une sorte de repos. Elles résistent alors à la dessiccation et même à de basses températures. Ce sont généralement ces levures désactivées qui sont proposées dans le commerce sous la forme de poudre ou de comprimés. Elles redeviennent actives dès qu'elles retrouvent les conditions idéales pour leur développement. L'application qui vient tout de suite à l'esprit est la boulangerie où les levures sont utilisées pour faire gonfler la pâte à pain. Lorsqu'elles se multiplient, le gaz carbonique dégagé sous forme de bulles fait gonfler la pâte.
D'autres types de levures agissent en milieu anaérobie. C'est le cas de celles qui sont utilisées dans les boissons alcoolisées comme le vin, la bière ou le cidre. Elles digèrent le sucre et le transforment en alcool sous l'action de la fermentation.
De nombreuses levures sont présentes dans l'air ambiant, c'est d'ailleurs elles qui rendent un liquide oublié au réfrigérateur un peu pétillant.
Les levures, sous la forme de poudres ou de comprimés sont aussi utilisées comme compléments alimentaires pour améliorer la santé des cheveux, des ongles, de la peau et pour assurer une meilleure capacité visuelle car elles produisent de la vitamine B2 (riboflavine) nécessaire pour la fabrication de nombreux enzymes.
Les moisissures
Les moisissures sont des champignons microscopiques se développant la plupart du temps à une température moyenne (entre 5 et 25°C) sur un fond nourrissant (matière organique, sucres, graisses, cellulose...), avec une quantité d'oxygène et un taux d'humidité importants. Les spores de moisissures sont présents dans l'air ambiant mais leur dimensions sont inférieures à 10 microns. Il existe de nombreuses variétés de moisissures se matérialisant en coloris tirant du verdâtre au noir. Lors de leur développement les moisissures produisent de nombreux spores, ce qui explique leur très rapide expansion. Parmi les plus connues, les espèces du genre Pénicillium avec lesquelles on produit la pénicilline, un antibiotique utile pour lutter contre diverses bactéries. Plusieurs autres espèces de Penicillium sont utilisées pour la fabrication de fromages dont le fameux roquefort ou le Bleu d'Auvergne. Les penicillium sont parfois visibles sur les aliments qu'ils recouvrent d'une poudre bleu-vert, tout le monde a d'ailleurs déjà pu observer un citron ou une orange couverts de cette substance.
Vos commentaires